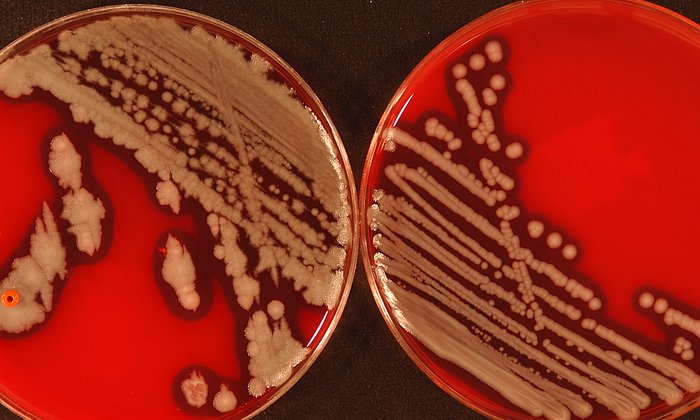
Typisches Wachstum von Bacillus cereus-Kolonien in Kulturschalen.

Erfahrener Hochschulmanager und erfolgreicher Wissenschaftler übernimmt die Führung
Thomas Hofmann wird neuer Präsident der TUM

Der Hochschulrat hat Prof. Thomas Hofmann heute für die sechsjährige Amtszeit ab 1. Oktober 2019 gewählt. Das Aufsichtsgremium der TUM besteht aus den zehn gewählten Mitgliedern des Senats und zehn externen Persönlichkeiten aus Wissenschaft, Wirtschaft und Politik.
„Es ist dem Hochschulrat gelungen, mit Professor Thomas Hofmann einen international renommierten Wissenschaftler und erfahrenen Hochschulmanager als nächsten Präsidenten der TUM zu gewinnen. Ich freue mich sehr über seine Wahl und auf die kommende Zusammenarbeit“, sagt Prof. Otmar Wiestler, Vorsitzender des Hochschulrats und Präsident der Helmholtz-Gemeinschaft.
Erfolge in der Exzellenzinitiative
Bei seinem Amtsantritt wird Thomas Hofmann zehn Jahre lang den Bereich Forschung und Innovation als Geschäftsführender Vizepräsident verantwortet haben. In dieser Zeit hat die TUM herausragende Erfolge erzielt, nicht zuletzt in der Exzellenzinitiative im Jahr 2012. Kern ihres Zukunftskonzepts als Exzellenzuniversität war das neue Berufungs- und Karrieresystem „TUM Faculty Tenure Track“, das Hofmann maßgeblich entworfen und etabliert hat. Weil es dem wissenschaftlichen Nachwuchs echte Aufstiegsperspektiven und frühe Unabhängigkeit bietet, wurde es zum Vorbild für das deutsche Wissenschaftssystem. Die TUM hat seither rund 100 herausragende junge Kollegiumsmitglieder von den besten Forschungseinrichtungen weltweit berufen (Offensive TUM100). Weitere 40 Professuren wurden der TUM im Bund-Länder-Programm 2017 zugesprochen.
Die TUM zählt zu den forschungsstärksten Universitäten Europas, was auch aufgrund der Erfolge des Wissenschaftsmanagements bei der Einwerbung von Forschungsfördermitteln möglich wurde. In Hofmanns Amtszeit als Vizepräsident gingen nahezu 100 ERC Grants an die TUM, die zu den höchstdotierten europäischen Forschungspreisen zählen. Sowohl 2012 als auch im vergangenen Monat hat die TUM mit ihren Partnern mehrere Exzellenzcluster zugesprochen bekommen. Hofmann selbst hat 2016 als Chairman eines europäischen Konsortiums die Knowledge and Innovation Community (KIC) „EIT FOOD“ beim European Institute of Technology eingeworben, bestehend aus rund 50 Partnern aus Wissenschaft und Industrie.
Neue Dimension bei Industriepartnerschaften und Gründungsförderung
Mit langfristigen, von Hofmann ausgestalteten Rahmenverträgen mit der Wirtschaft ist die TUM in neue Dimensionen vorgestoßen, darunter Kooperationen mit den innovativsten Global Playern wie zuletzt Google. Er trieb außerdem die „Industry on Campus“-Strategie voran, um Unternehmen als Forschungspartner unmittelbar auf dem Campus Garching anzusiedeln, so etwa Siemens und SAP.
Unter Hofmanns Leitung erreichte die TUM eine Führungsposition bei Unternehmensgründungen. Inzwischen werden hier jedes Jahr rund 70 Technologie-Start-ups gegründet, was die TUM ausweislich der einschlägigen Rankings zur gründungsfreundlichsten Universität Deutschlands macht.
Forschung und Lehre in der Lebensmittelchemie
Der künftige Präsident hatte im Jahr 2002 den Lehrstuhl für Lebensmittelchemie an der Universität Münster erhalten. 2007 berief ihn die TUM auf den neu eingerichteten Lehrstuhl für Lebensmittelchemie und Molekulare Sensorik. Zeitgleich lehnte er einen Ruf an die ETH Zürich ab. Seit 2015 ist Hofmann Co-Direktor des Bayerischen Zentrums für Biomolekulare Massenspektrometrie (BayBioMS) an der TUM, seit 2017 Direktor des mit der TUM assoziierten Leibniz-Instituts für Lebensmittel-Systembiologie.
Der 50-Jährige forscht und lehrt zu Stoffen in Pflanzen und verarbeiteten Lebensmitteln, die für das Geschmacks- und Geruchsempfinden sowie den Stoffwechsel des Menschen relevant sind. Sein Spektrum reicht dabei von der biomolekularen Grundlagenforschung bis zur Entwicklung industriell anwendbarer Analyseverfahren. Hofmann hat international beachtete Forschungserfolge erzielt und das Studienangebot der TUM in der Lebensmittelchemie maßgeblich geprägt.
Nachfolger des dienstältesten Universitätspräsidenten Deutschlands
An der Spitze des Präsidiums der TUM wird Thomas Hofmann am 1. Oktober 2019 auf Wolfgang A. Herrmann (70) folgen. Der dienstälteste Universitätspräsident Deutschlands hat seit 1995 eine neue Ära der TUM als „unternehmerische Universität“ und Reformmotor für das deutsche Wissenschaftssystem geprägt. „Thomas Hofmann ist ein Glücksfall für die TUM und die deutsche Hochschullandschaft“, freut sich Herrmann. „Er wird unsere Universität mit eigenen unternehmerischen Akzenten bruchlos in die Zukunft führen. Die Gesamtstrategie im Rahmen der kommenden Exzellenzinitiative trägt bereits wesentlich die Handschrift des neuen Präsidenten. Der Generationenwechsel an unserer Universität erfolgt lautlos, aber effizient.“
Mehr Informationen:
Interview mit Prof. Thomas Hofmann im BR (4:38 Min)
Die Verfügbarkeit von Inhalten in Mediatheken ist unter Umständen zeitlich begrenzt.
Technische Universität München
Corporate Communications Center
- Klaus Becker
- klaus.becker@tum.de
- presse@tum.de
- Teamwebsite